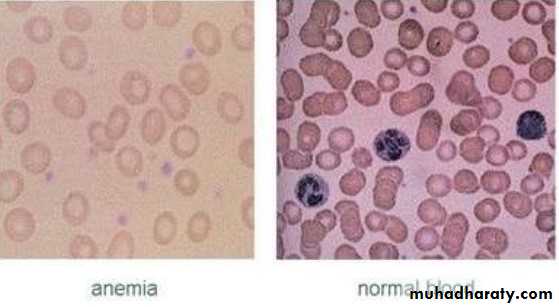
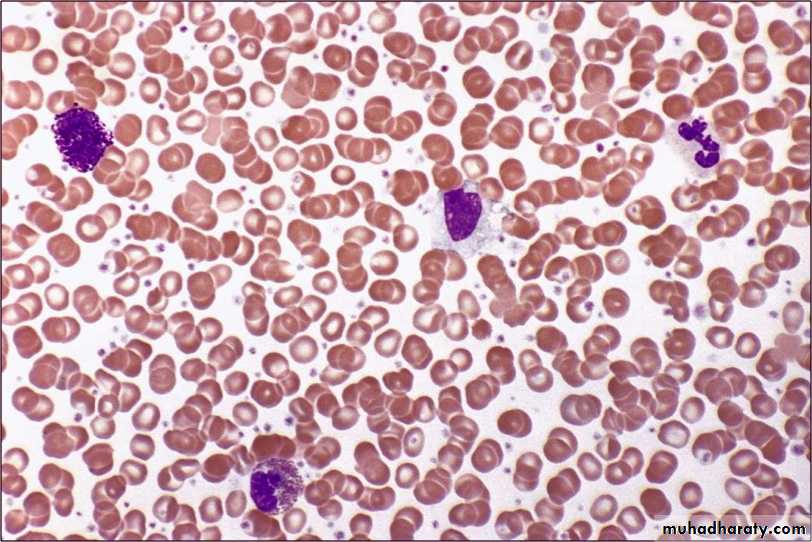

Blood dyscrasias
Medically compromised patientBlood dyscrasias
Blood dyscrasias: is a pathologic condition of the blood, usually referring to a disorder of the cellular elements of the blood.These are grossly divided into; disorders of the red blood cells RBCs (erythrocytes) and disorders of the white blood cells WBCs.
Disorders of the RBCS
AnemiaReduction in the oxygen carrying capacity of the blood, it is associated with the decreased number of circulating RBCs or abnormalities in the Hemoglobin Hb contained in the RBCs, which is the oxygen carrying molecule of the erythrocytes, it is also responsible for the transport of CO2.
Hb is a heterogeneous group of proteins consisting of 4 globin chains and 4 haem (heme) groups.
In anemia Hb level is below l2 g/dl in adult female and below 13 g/dl ln adult male
Anemia is not a disease but rather a feature or symptom that results from many underlying causes.
Types of anemia:
• Deficiency anemias:• Iron deficiency anemia: it is caused by blood loss, poor iron intake, poor iron absorption or increased demands for iron. It is more common in women than in men due to blood loss during menstruation and pregnancy.
• Vitamin Bl2 (cobalamin) deficiency , folate (Folic acid) deficiency and Pernicious anemia:
• Vit. Bl2 and folic acid are needed for RBCs formation and growth within the bone marrow. Vit Bl2 is bound to gastric intrinsic factor secreted by the parietal cells and absorbed in the terminal ileum, deficiency of the intrinsic factor causes Pernicious anemia.
• Hemolytic anemias:
Hemoglobinopathies : these are inherited abnormalities of the Hb formation like Sickle cell anemia and Thalassemia.Inherited abnormal function or structure of erythrocytes:
Erythrocyte metabolic defects as in Glucose 6-Phosphate dehydrogenase deficiency (G6PD). And Erythrocyte membrane defects as in Spherocytosis, ovalocytosis and Stomatocytosis .
Damage to erythrocytes : which could be autoimmune, drug induced or infective. World wide Malaria is the most common cause of hemolytic anemia.
• Other anemia’s:
Aplastic anemia: it is a pancytopenia with anon-functioning bone marrow, many cases are idiopathic but possible causes include:Chemical like Benzene, drugs, hepatitis virus, irradiation and graft versus host disease.
Anemia caused by bone marrow in infiltration by abnormal cells:
like ln Leukemia and Multiple Myloma.
Anemia associated with systemic diseases:
like in chronic inflammation and connective tissue diseases such as Rheumatoid Arthritis, Liver disease, Hypothyroidism, Hypopituitarism Hypoadrenocorticism ,Uremia and HIV infections
Clinical presentation
in the early stage there are no signs and symptoms. Later symptoms include: fatigue, palpitations, dyspnea, bone and abdominal pain and tingling of the fingers and toesSigns include:
jaundice, pallor, brittle nails and Koilonychia (spoon shaped nails). There may be hepatosplenomegaly and LAP.
Oral manifestations :
Pale mucosaoral ulcerations
angular cheilitis
glossitis
loss of papillae
atrophic changes in the mucosa
patients with iron deficiency anemia may develop Plummet-Vinson syndrome and burning mouth symptoms.
In patients with hemolytic anemia, there may be oral evidence of oral jaundice due to excessive red cells destruction
Osteomyelitis, necrosis and peripheral neuropathy.
Dental hypoplasia and delayed eruption of teeth often occur.
Laboratory tests :
These include:Hb.
hematocrit and RBCs indices (MCV, MCI-I, NICHC),
total WBCs count,
platelet count.
More special tests may be needed to further distinguish the various types of anemia.
Medical management:
the goal is to eliminate the underlying causes.• ln deficiency anemias :
• replacement of iron or folic acid. patients with pernicious anemia can be managed by Cyanocobalamin injections.
• Blood transfusion may be needed when the Hb level falls below 7 g/dl and hematocrit (PCV) is below 20%.
• Erythropoietin is used in treatment of anemia of chronic renal failure or cytotoxic drugs
• Patients with Sickle cell anemia may require prophylactic Penicillin to. prevent infections.
Dental management
• History, the questions should include history of dietary intake, malnutrition, alcohol or drug use, history of blood ’ loss especially for women during menstruation and pregnancy. The clinician should also identify signs and symptoms of anemia and can also order some screening tests, if the results of one of the tests or more are abnormal, the patient should be referred for medical evaluation and treatment.• the clinician should ensure that the patient's underlying condition is under therapeutic control before proceeding with routine dental care. Patients with signs and symptoms of anemia and Hb level below 11 g/dl with abnormal heart rate or reduced oxygen saturation (below 91% in oximetry) are considered unstable and routine dental treatment should be deferred.
• Local anesthesia (LA) is satisfactory for pain control, conscious. sedation can be given only if there is supplemental oxygen, elective operations under general anesthesia (GA) are not carried out when Hb level is below 10 g/d1.
• In patients with G6PD deficiency, certain drugs should be avoided since they can cause hemolysis, such as Sulfonamides (Sulfamethoxazole), Aspirin, Chloramphenicol and to a lesser extent Penicillin, Streptomycin and lsoniazide. Also dental infections should be avoided and if they occur they should be treated effectively.
• In patients with Sickle cell anemia, routine dental care can be provided for stable patients during non-crisis period, appointments should be short and the procedures should be not complicated, oral infections should be avoided, LA without vasoconstrictor for routine dental care is used while for surgical procedures LA with vasoconstrictor 1:100000 can be used. Barbiturates and strong narcotics should be avoided and Diazepam used when sedation is needed, prophylactic Antibiotics for surgical procedures are used, liberal use of Salicylates should be avoided and pain control can be achieved with acetaminophen (Paracetamol) and Codeine. In general infection, dehydration, hypoxia, acidosis and cold should be avoided in patients with Sickle cell anemia because the ' can precipitate acute crisis.
Polycythemia
It is an expansion mainly in the red cell population, it may be primary and idiopathic associated with normal erythropoietin level (Polycythemia Rubra Vera) PRV. It can also be secondary to tumors that release erythropoietin hormonePRV is a disease of elderly and of smokers, it has a slight male predilection.
Diagnosis of polycythemia is made when Hb level is above 16.5 g/dl and hematocrit 48% in women and when Hb is above 18.5 g/dl and hematocrit 52% in men.
•
Clinical presentation
• Hyper-viscosity of blood leading to thrombosis due to changes in platelets and clotting mechanisms which may cause Stroke and Myocardial Infarction.• Pruritus.
• Granulocyte overproduction leading to Hyperuricemia, Gout and renal failure.
• Hemostatic defects
• Bone pain due to replacement of bone marrow with erythropoietic tissues.
General management
• Repeated venesection which involves blood letting or drawing of blood as in donation of blood.
• Cytotoxic drugs (Busulphan, Chlorambucil or Melphalan) may be given to suppress marrow activity.
• Cyproheptadine to control pruritus.
• Allopurinol for Gout if needed
Dental management
• LA regional blocks should be avoided if possible.• Conscious sedation can be given.
• GA is allowed.
• Susceptibility to thrombosis and hemorrhage should be considered.
• Cytotoxic chemotherapy may cause oral complications that require management.
WBCS DisordersLeukemia
WBCS Disorders
Leukemials cancer of the WBCs that affects the bone marrow and circulating blood. it involves proliferation of lymphoid or myeloid cells. Leukemia ls classified by the clinical course into: acute and chronic, and by the cell of origin into: lymphoid or myeloid (non-lymphoid). In acute leukemia there is a rapidly progressive disease that result from accumulation of immature, functionless WBCS ln the bone marrow and blood, it is more common than chronic leukemia. While in the chronic leukemia there ls slower onset and the cells are more mature
There are 4 types of leukemia with many subtypes:
• Acute Lymphocytic Leukemia ALL, it is the most common type in children.
• Acute Myeloblastic Leukemia AML, the most common type in adults.
• Chronic Lymphocytic Leukemia CLL, the second most common type in adults.
• Chronic Lymphocytic Leukemia CML.
Clinical presentation
Include:fatigue, easy bruisibility, bone pain, anemia, thrombocytopenia, malaise, pallor, anorexia, dyspnea on exertion, bleeding tendency, petechiae pallor ecchymoses of the skin and mucous membrane, recurrent infections, fever, weight loss, LAP, enlargement of the spleen and CNS disease.
Diagnosis is made by examination of the peripheral blood and bone , marrow.
General management
It consists of chemotherapy to reduce the number of the malignant WBCs The other line of treatment is bone marrow transplantation and peripheral blood stem cell transplantation.Oral manifestations
Are more common in acute leukemia than in chronic leukemia, they include:• localized or generalized gingival enlargement.
• The gingiva bleeds easily
• oral ulcerations.
• Recurrent oral infections.
• Localized mass of leukemic cells ln the gingiva and other site of the oral cavity, it is termed Chloroma (Granulocytic Sarcoma).
• Pallor of oral mucosa.
• LAP
Lymphoma
Lymphoma is a solid malignant tumor that originate in the lymph nodes or extra-nodal lymphoid tissues in any part of the body.Lymphoma Comprises Hodgkin's lymphoma or disease and non-Hodgkin's lymphoma NHL.
NHL is more common than the Hodgkin's type.
Hodgkin's disease; it is a neoplasm of B lymphocytes, it contain a characteristic tumor cell (Reed Sternberg cell). The cause is unknown but EBV may be implicated. '
it present as a painless enlargement of non-tender lymph nodes involving head and neck, axillary, mediastinal or groin lymph nodes.
Fever, night sweats, fatigue and weight loss may be experienced by the patient.
The diagnosis is based on nodal biopsy and bone marrow aspirate.
Medical management requires staging on the basis of history, physical examination, lab. Findings and imaging.
Non-Hodgkin’s lymphoma: a large group of lymphoproliferative disorders or either B lymphocytes (more than 80% of the cases) or T lymphocytes origin.
The cause is unknown but some genetic factors and chromosomal . abnormalities in addition to other environmental factors such as infection with EBV, irradiation and drugs were implicated as possible causative factors.
The clinical presentation include:
LAP,fever
Weight loss
abdominal or chest pain .
Extra nodal tumor.
The diagnosis is based on biopsy of the lymph nodes or extra-nodal tumor. Proper staging is required which consists of blood investigation imaging and bone marrow biopsy
Medical management of lymphoma generally consist of chemotherapy and radiotherapy.
Oral manifestations• Cervical LAP.
• Intraoral tumors that may involve Waldeyer's ring salivary glands, mandible, palate, gingiva or floor of the mouth.
• Oral ulcerations.
• Oral complications secondary to treatment include;
• burning mouth symptoms,• xerostomia,
• infections,
• trismus,
• impaired cranio-mandibular growth
• and osteoradionecrosis.
Burkett's Lymphoma
It is an aggressive type of B cell NHL. It is the most common lymphoma of children.Types of Burkett's lymphoma:
• the endemic or African type.
• non-endemic type, occurs in western societies.
• recently described type associated with HIV infected individuals.
Oral manifestations
Include: tumors of the maxilla or mandible that cause :• bone destruction
• mobility of the teeth,
• pain and paresthesia.
• On radiograph it. appears as an osteolytic lesion with poorly demarcated margins.
Medical management is by combination chemotherapy.
Multiple Myeloma
It is a lymphoproliferative disorder that results from overproduction of cloned malignant plasma cells resulting in bony lesions involving the skeletal system.
Clinical presentation :
The malignant cell proliferation cause bone resorption that appear radiographically as a radiolucent punched out lesions and replace bone marrow leading to anemia , leucopenia , thrombopenia.
There is Amyloid deposition in various tissues that may lead to renal failure. Infection is common. The most prominent symptom is persistent bone pain affecting the spine, ribs and sternum, weight loss, headache and Hypercalcemia.
Medical management
• High dose chemotherapy and Prednisone• Which can be followed by bone marrow transplantation
• or autologous stem cell transplantation
• Treatment of anemia by erythropoietin.
• Antibiotics to prevent and treat infections.
• Bisphosphonates are used to reduce bone pain and maintain bone strength.
Oral manifestations:
• Painful bony lesions, that appear as osteolytic punched out lesions which may be associated With cortical bone expansion.• Extra-medullary plasma cell tumor.
• Deposition of Amyloid in soft tissues like tongue.
• Osteonecrosis of the bone associated with Bisphosphonates treatment, it usually appears after surgery especially tooth extraction as a painful, non-healing socket. Treatment is directed to limiting the progression of necrosis through debridement, irrigation with antiseptics and antibiotics.
To minimize the likelihood of developing necrosis:
• Early treatment of any source of odontogenic infection preferably before starting treatment with Bisphosphonates.
• Non-surgical approaches are to be preferred.
• If extraction is required it should be as conservative as possible.
• The risk of necrosis should be discussed with the patient.
Dental management of WBCS Dyscrasias
• History about the signs and symptoms of these disorders, such as easy bruising or bleeding tendency, also family history of WBCs disorders,• Thorough extra-oral and intraoral examination of the head and neck, oral cavity and oropharynx to identify any abnormalities that are suggestive of WBCs disorders.
• Screening blood investigations may be needed and if the results are abnormal, the patient is referred for further evaluation and routine dental care can be deferred
Dental management of patients with diagnosed Leukemia, Lymphoma and Multiple Myeloma
It involves the three phases of the medical therapy:• Pretreatment assessment and preparation of the patient:
• the aim of this phase is to prevent oral infections, through restorative, periodontal and surgical treatment preferably 2 weeks prior to medical treatment.
• Oral hygiene measures should be encouraged.
• When extraction is planned it should be as conservative as possible avoiding any hemostatic packing agents and attaining primary closure.
• Prophylactic antibiotic are recommended before oral surgical procedure.
• 2 g of Amoxicillin one hour before the procedure, 500mg 3 times daily for one week.
• Patients with platelet count below 50.000/mm3 should not undergo oral surgical procedures unless correction by transfusion is carried out.
• Oral health care during medical treatment:
• during treatment the patient is susceptible to many oral'complications that require care:• Mucositis: appear 7-l0 days after initiation of treatment and resolve after it. The non-keratinized mucosa is more severely affected. Oral hygiene measures should be maintained to minimize infection, antiseptic and antimicrobial mouth washes e. g. Chlorhexidine are ‘ recommended, topical anesthetics and systemic analgesics can be ' given.
• Neutropenia and infection: neutropenia leads to gingival inflammation, oral ulceration and infection which can be severe but with minimal clinical signs. Unusual bacterial infections, fungal and viral infections occur in patients with Leukemia, Lymphoma and Multiple Myeloma on chemotherapy and require treatment. When oral infections develop, a specimen of the exudate should be sent for culture and antibiotic sensitivity tests.
• Bleeding: thrombocytopenia may case submucosal hemorrhage ' and sometimes spontaneous gingival bleeding, oral hygiene measures should be improved, when bleeding Occurs local hemostatic measures should be used first like using pressure, gelatin sponge with thrombin or the use of oral anti- fibrinolytic agents. If these measures fail transfusion may be needed.
• Graft versus host disease: it occurs after bone marrow transplantation when immunologically active donor T cells react against host tissues, it can be acute (within 2-3 weeks) causing rash, mucosal ulcerations, increased liver enzymes and diarrhea. Or it could be chronic (3-12 months) producing features like Sjogren syndrome, scleroderma, lichenoid changes, xerostomia, mucositis, dysphagia and damage to liver. It Can be prevented by corticosteroids and immunosuppressive drugs.
• Adverse effects of drugs; such as gingival overgrowth with patients taking Cyclosporine.
• Disturbance of growth and development; due to treatment with chemotherapy and radiotherapy during childhood leading to micrognathia, malocclusion and teeth abnormalities.
• Post-treatment management:
• patients in remission state can have routine dental care While patients with poor prognosis should receive emergency care only.• When invasive procedures are planned (e. g. oral surgery), platelet count and bleeding time should be investigated, the patient’s physician should be consulted.
• In patients With surgically removed spleen, prophylactic antibiotic is needed, since they are at risk of bacterial infections, especially in the first 6 months after splenectomy.
• In patients with acute symptoms, routine dental care should be deferred. LA regional block should be avoided if possible in patients with bleeding tendency. Conscious sedation can be given and GA is allowed.